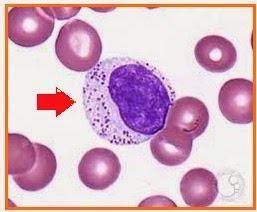

Iklan
Pertanyaan
Perhatikan gambar di bawah ini!
Yang ditunjukkan oleh anak panah merupakan leukosit yang berfungsi untuk....
pembentuk antibodi
menguraikan antigen
menghancurkan antigen
menurunkan jumlah antibodi
memakan kuman penyakit
Iklan
A. Acfreelance
Master Teacher
16
3.8 (10 rating)
Chayra Alesha Lubna H
Makasih ❤️ Mudah dimengerti Bantu banget Pembahasan lengkap banget
Sintiana Arini
Ini yang aku cari!
Rachel Carmichael
ga lengkap
Adelia Zahra
Pembahasan tidak lengkap
Iklan
RUANGGURU HQ
Jl. Dr. Saharjo No.161, Manggarai Selatan, Tebet, Kota Jakarta Selatan, Daerah Khusus Ibukota Jakarta 12860
Produk Ruangguru
Bantuan & Panduan
Hubungi Kami
©2025 Ruangguru. All Rights Reserved PT. Ruang Raya Indonesia